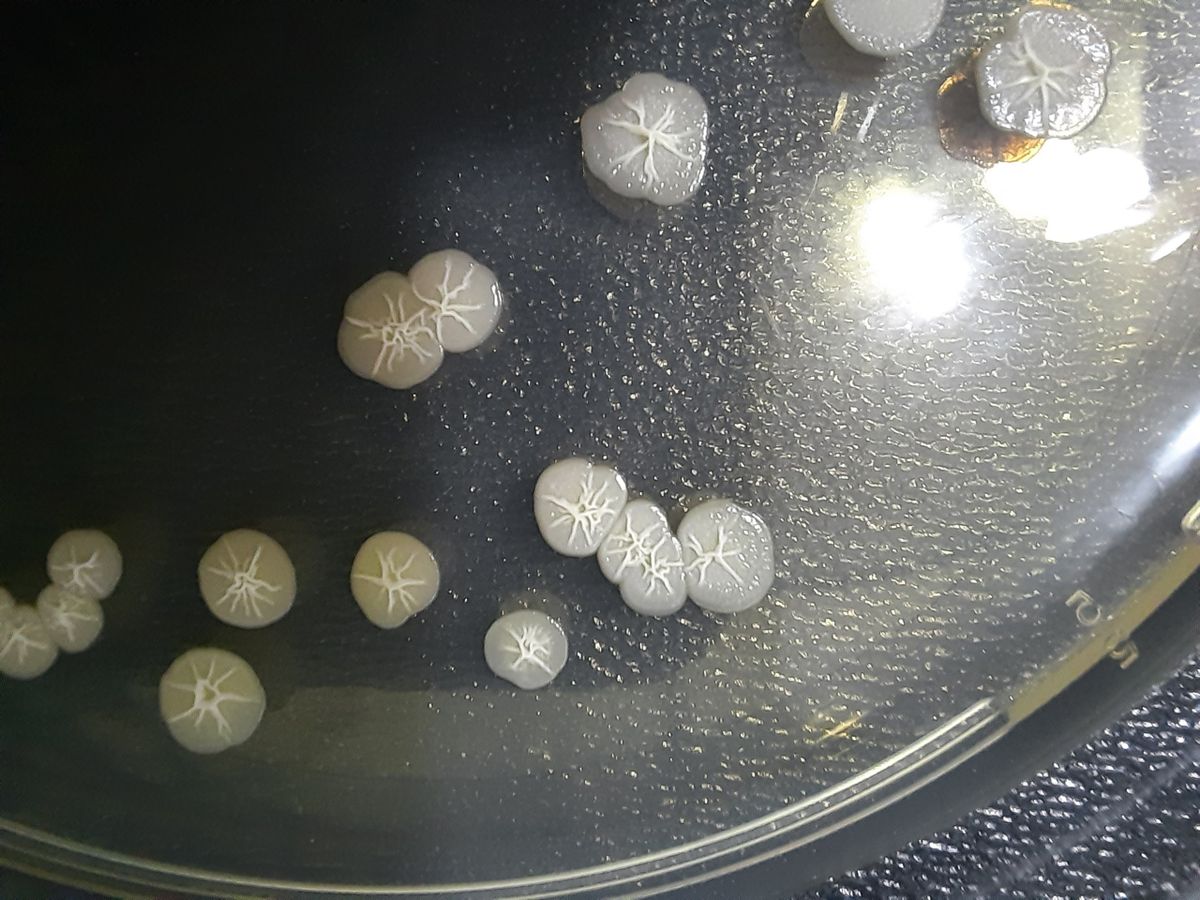

Bacillus pumilus - Nguyên liệu vi sinh đơn dòng giá sỉ - giá bán buôn
1 lượt liên hệ
Sản phẩm này đã ngưng kinh doanh. Vui lòng tìm các sản phẩm khác tương tự trên Thị Trường Sỉ
Tìm sản phẩm nàyNguyên liệu vi sinh đơn dòng Bacillus pumilus
Xuất sứ: CTY CP Phát triển và ứng dụng công nghệ vi sinh MDA
Hàm lượng:
Mật độ vi khuẩn 1 x 10 ^9 cfu/g , 1 x 10^10 cfu/g 5×10^10 cfu/g tùy theo ứng dụng và nhu cầu của khách hàng
Tính năng:
- Ức chế sinh học vi khuẩn gây hại
- Cải thiện tỉ lệ chuyển đổi thức ăn (FCR)
- Tăng cường khả năng miễn dịch,bảo vệ chống lại các bệnh về đường tiêu hóa
- Xử lý môi trường
- Có khả năng sinh tổng hợp một số chất kháng sinh, có tác dụng ức chế sinh trưởng hoặc tiêu diệt một số vi sinh vật khác, tác dụng lên cả vi khuẩn gram(-) vi khuẩn gram (+) và nấm gây bệnh.
Phạm vi ứng dụng
- Làm nguyên liệu điều chế các chế phẩm men vi sinh, Probiotics, chất bổ sung thức ăn chăn nuôi, chế phẩm xử lý dùng trong Thú y, Thủy sản và Xử lý Môi trường.
Ưu điểm sản phẩm
- Chủng vi sinh được nghiên cứu và sản xuất chuyên biệt, hoạt lực chủng mạnh.
- Vi sinh ở dạng bào tử nên chịu được nhiệt độ cao trong quá trình đóng gói và bảo quản, giúp đảm bảo mật số vi sinh ổn định khi sử dụng.
- Hoạt động tốt ngay cả trong điều kiện oxy thấp đặc biệt ở vùng tập trung chất thải ở đáy ao, và độ mặn dao động từ 0 – 45‰.
- Cam kết sản phẩm ổn định, không chứa các loại kháng sinh và hóa chất.
- Sản phẩm đến trực tiếp Quý Khách, không qua trung gian giúp giảm giá thành sản xuất cho Quý Khách hàng, nâng cao lợi nhuận.
Tên nhà cung cấp:
CTY CP Phát triển và Ứng dụng Công nghệ Vi sinh MDA
Địa chỉ:
H. Thạch Thất, Hà Nội
Tham gia từ:
2021
Ngành hàng buôn bán:
Sản phẩm tương tự
Bạn cũng có thể thích
Sản phẩm đã xem
Chưa tìm được thứ bạn cần? Hãy để nhà cung cấp liên hệ đến bạn
Gửi 1 yêu cầu báo giá, nhận nhiều lượt báo giá từ hơn 60,000 nhà cung cấp
Bạn có biết: Tìm sản phẩm để mua sỉ trên Google nhanh hơn với cú pháp: tên sản phẩm + thitruongsi. Ví dụ: áo thun trơn giá sỉ thitruongsi